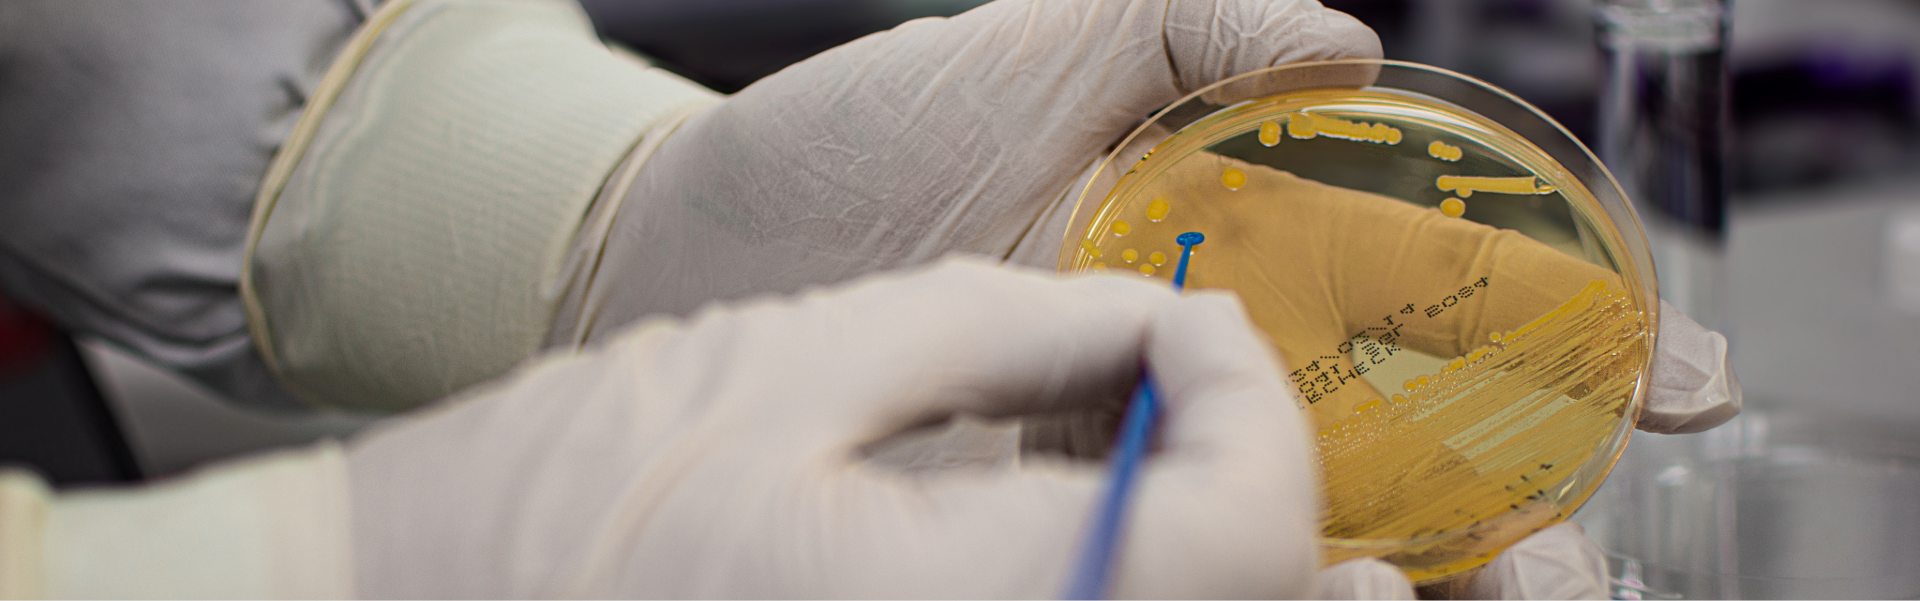

Services De Tests Microbiologiques
Répondent aux besoins de validation de la stérilisation et de tests de laboratoire de nos clients des secteurs pharmaceutique et médical. Nous fournissons un interlocuteur unique pour chaque étape du processus conceptuel de la stérilisation, depuis le développement du produit jusqu’aux opérations courantes de traitement. Nos laboratoires de microbiologie sont pleinement agréés et satisfont aux exigences des normes ISO11135 et ISO11137. Consultez la liste complète de nos services de tests microbiologiques ci-dessous

